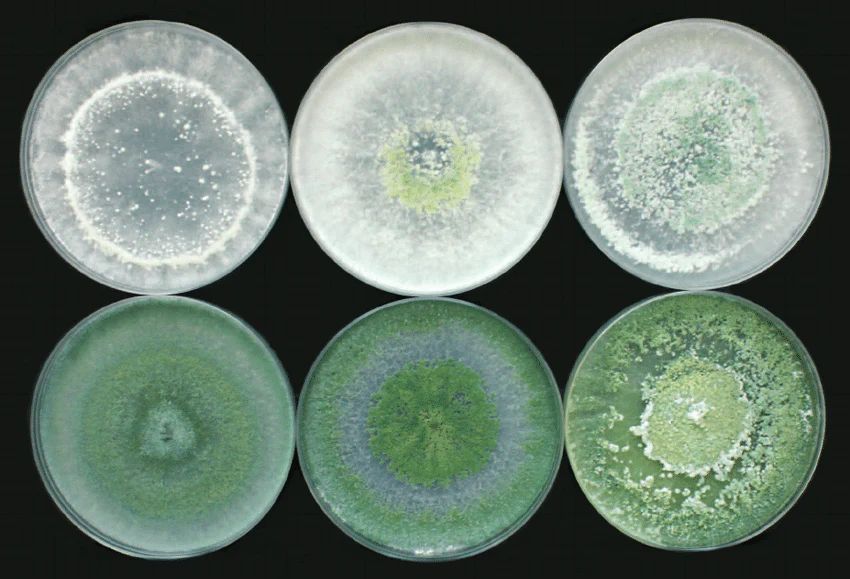

Значение триходермы в агрономии
С каждым годом триходерма становится все более популярной в мире сельского хозяйства и садоводства. Этот удивительный гриб не только эффективно борется с растительными патогенами, но и способствует росту культур, укрепляя корневую систему и активируя обмен питательных веществ. Триходерма известна еще с начала 1900-х годов как источник полезных ферментов в различных промышленных отраслях, но её настоящие достоинства стали ясны только в последние несколько десятилетий.
Как триходерма помогает растениям
Под видом гриба триходерма обитает в почве, на гниющей древесине и на корнях растений. Она ускоряет разложение сложных органических соединений, превращая их в доступные для растений питательные вещества. В процессе своей жизнедеятельности триходерма выделяет мощные антибиотики и ферменты, которые подавляют рост патогенных организмов, таких как Pythium, Fusarium и Rhizoctonia.
Основные преимущества триходермы:
- Биофунгицид: Её можно наносить на семена и листья, а также вносить в почву. Триходерма будет конкурировать с патогенами за ресурсы и пространство.
- Удобрение: Гриб способствует растворению фиксированных фосфатов, делая их доступными для растений, что значительно улучшает их рост.
Применение триходермы
Использовать триходерму можно как профилактическое средство — на ранних стадиях заболеваний. Если проблема уже проявилась, рекомендуется регулярная обработка жидкими препаратами триходермы, что позволит эффективно остановить распространение болезни. Споры патогенных грибов быстро распространяются, и хроническое заболевание при отсутствии должной профилактики может обернуться большими проблемами.
Важно помнить, что при использовании триходермы необходимо следить за дозировкой. Переизбыток может негативно повлиять на рост растений. Это живой организм, который при неправильном использовании может стать источником проблем, поэтому следует следовать инструкциям по применению.